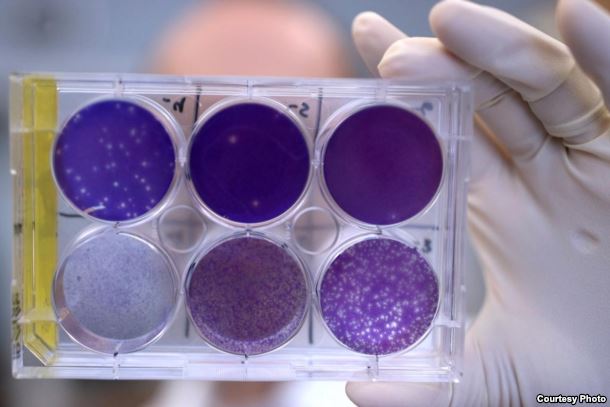

Ngày 7/11/2016. VOA News-Kháng thế được xem là bước đột phá trong cuộc chiến chống virus Zika (Antibody Seen as Breakthrough in Fight Against Zika). Trong bước đột phá tiềm năng chống lại virus Zika, các nhà nghiên cứu đã phát hiện ra một loại kháng thể có khả năng có thể được chế tác thành một loại vaccine để bảo vệ phụ nữ mang thai chống lại virus do muỗi truyền.
Được gọi là ZIKV-117, kháng thể hay protein hệ miễn dịch được phân lập từ một bệnh nhân đã bị nhiễm virus Zika.Trong một nghiên cứu ở những con chuột mang thai bị nhiễm mầm bệnh do muỗi truyền, ZIKV-117 bảo vệ thai nhi chống lại tình trạng nhiễm bệnh,kháng thể kích thích đáp ứng của hệ miễn dịch chống virus mạnh mẽ và vô hiệu hóa tất cả các chủng Zika đã được thử nghiệm. Số lượng virus ở người mẹ đã được làm giảm đáng kể, giảm mức độ tác nhân gây bệnh được tìm thấy ở nhau thai của thai nhi và mô não.
Một nhà nghiên cứu giữ một khay virus Zika nuôi cấy trong các tế bào động vật tại Đại học Y khoa Washington ở St Louis, Missouri.
Các nhà nghiên cứu đã xác định được một kháng thể ở người có thể ngăn chặn, ở những con chuột mang thai,
thai nhi tránh không bị nhiễm bệnh và nhau thai không bị tổn thương, kháng thể cũng bảo vệ những con chuột trưởng thành tránh nhiễm Zika.
(Photo courtesy of Huy Mach)
Chuột đực bị nhiễm bệnh cho một liều ZIKV-117 duy nhất có nhiều khả năng sống sót hơn so với chuột không được điều trị, thậm chí năm ngày sau khi bị nhiễm Zika cho thấy kháng thể có thể được sử dụng để điều trị một ca nhiễm bệnh. Phát hiện này đã được thực hiện bởi các nhà nghiên cứu tại Đại học Y khoa Washington ở Missouri và Đại học Vanderbilt ở Tennessee báo cáo trên tạp chí Nature.
Phát hiện đầu tiên chống virus Zika (A first against Zika)
Theo Michael Diamond, nhà vi sinh học và miễn dịch học tại Đại học Washington là đồng tác giả chính của nghiên cứu thì đây là lần đầu tiên trong bất kỳ phương pháp điều trị nào dành cho Zika đã được tìm thấy. Ông cho biết: "Trước nghiên cứu này, không có vaccine hay bất kỳ nghiên cứu nào khác đã thực hiện ở động vật mang thai cho thấy bất cứ điều gì có thể hủy bỏ hoặc ngăn ngừa bệnh chứng tỏ các kháng thể có khả năng làm điều đó và đây thực sự là tín hiệu tốt cho những nỗ lực phát triển vaccine tương lai". Các nhà nghiên cứu sàng lọc 29 kháng thể chống Zika từ 5 người đã phục hồi từ Zika. ZIKV-117 đã được xác định trong một cá thể bị một nhiễm trùng nhẹ. Diamond cho biết thêm: "Đó là lý do mà kháng thể này xuất hiện như là phần tinh túy nhất nếu bạn có nó và đó là đỉnh điểm của sự tìm kiếm, hóa ra nó ức chế virus trong nuôi cấy tế bào tốt nhất, sau đó chúng tôi kiểm tra xem liệu những gì nó có thể tác dụng với việc bị nhiễm virus Zika hay không bằng cách sử dụng mô hình động vật trong trường hợp này, một mô hình bị bệnh ở chuột". ZIKV-117 được chứng minh là có hiệu quả trong phòng thí nghiệm trong việc vô hiệu hóa 5 chủng khác nhau từ khắp nơi trên thế giới.

Vật liệu phòng ngừa lây nhiễm Zika bởi muỗi được trưng bày tại kỳ họp của WHA lần thứ 69 tại trụ sở châu Âu của Liên Hiệp Quốc (UN)tại Geneva, Thụy Sĩ, ngày 23/5/2016
Phạm vi mang tính toàn cầu (Global reach)
Loại virus này càn quét khắp châu Mỹ, từ Brazil đến Trung Mỹ và các ca bệnh đã được báo cáo tại Hoa Kỳ. Cũng có những ca nhiễm Zika ở châu Phi, châu Á và khu vực Thái Bình Dương làm các quan chức y tế công cộng lo ngại căn bệnh mới nổi này trở thành mối đe dọa toàn cầu. Zika có thể gây ra các dị tật bẩm sinh nghiêm trọng, đặc biệt là tật đầu nhỏ ở những đứa trẻ của phụ nữ mang thai bị nhiễm virus, trẻ sơ sinh dị tật đầu nhỏ có bộ não và đầu nhỏ bất thường. Zika cũng được cho là gây ra một tình trạng bệnh lý thần kinh hiếm gặp, gây liệt ở người lớn được gọi là hội chứng Guillain-Barre. Theo Diamond, các nhà nghiên cứu đang chuẩn bị thử nghiệm kháng thể ở khỉ, một quá trình mà ông cho rằng có thể mất từ 6 đến 9 tháng, nếu những thí nghiệm này thành công thì việc thử nghiệm trên người có thể bắt đầu ngay sau đó và ZIKV-117 có thể được phát triển thành một loại thuốc có thể được sử dụng theo một số cách: "Hoặc là bạn dùng cho ai đó trước khi đi vào vùng nguy cơ cao hoặc ngay sau khi họ biết mình đang mang thai mà không bị nhiễm hoặc có thai và sau đó bị nhiễm bệnh ở giai đoạn đầu thì sử dụng nó vẫn có tác dụng". Do Zika có thể lây truyền qua đường tình dục nên ZIKV-117 cũng có thể dùng cho nam giới bị nhiễm bệnh nhằm ngăn chặn virus 'lây lan cho các đối tác bạn tình của họ, các nhà nghiên cứu đang tìm kiếmxem liệu kháng thể có thể điều trị các ca nhiễm từ lâu hay không nhưng Diamond cho rằng có bằng chứng sớm là Zika có thể gây vô sinh ở nam giới, virus có thể tồn tại lâu dài trong mắt và tinh hoàn.